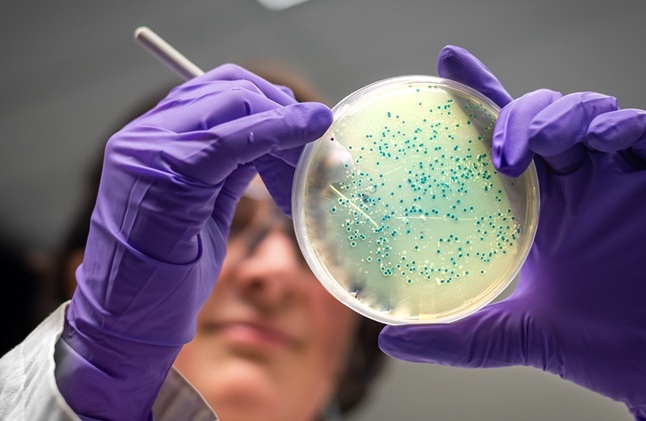

Capacitación
Te invitamos a capacitarte con nuestro equipo de especialistas en Genómica Nutricional. Sabemos que en cada paciente se entrelazan ADN, entorno y elecciones. La Genómica Nutricional puede abrir una nueva dimensión de acompañamiento clínico: más precisa, más humana, más transformadora.
¿Qué hace única esta capacitación?
- Enfoque clínico y práctico, basado en evidencia científica.
- Acompañamiento directo con expertos en genética y nutrición.
- Casos reales y guía para la aplicación inmediata en consulta.
- Interpretación ética y responsable del perfil genético del paciente.
Prepárate con:
- Webinars
- Capacitación directa
- Master class
- Diplomado
• Lo que aprendes, cambia lo que puedes ofrecer. Pero lo que comprendes, transforma cómo acompañas.
Si estás listo/a para integrar ciencia de vanguardia con una práctica profundamente humana, este espacio es para ti.
• Contáctanos para más información o para reservar tu lugar en la próxima capacitación.

Consultoría
Adaptamos la práctica clínica hacia un mejor desempeño con el uso de herramientas de Genómica Nutricional. Podemos aplicar Genómica Nutricional en:
Investigaciones
Productos
Proyectos
Servicios
Tratamientos
Aplicamos Genómica Nutricional en tus proyectos o en los productos y servicios que ofreces a tus clientes. Acercamos el conocimiento y las herramientas de vanguardia para que logres el objetivo que buscas.
Investigación
Todas las herramientas que ponemos en tus manos cuentan con un respaldo científico realizado a través de investigación propia e investigaciones publicadas.
En EPIOMA la investigación nunca para, todos nuestros productos y servicios están basados en investigaciones de alto nivel científico publicadas en el campo de la genómica nutricional que combinado con investigaciones propias generan la innovación, mejora continua y nuevas herramientas.